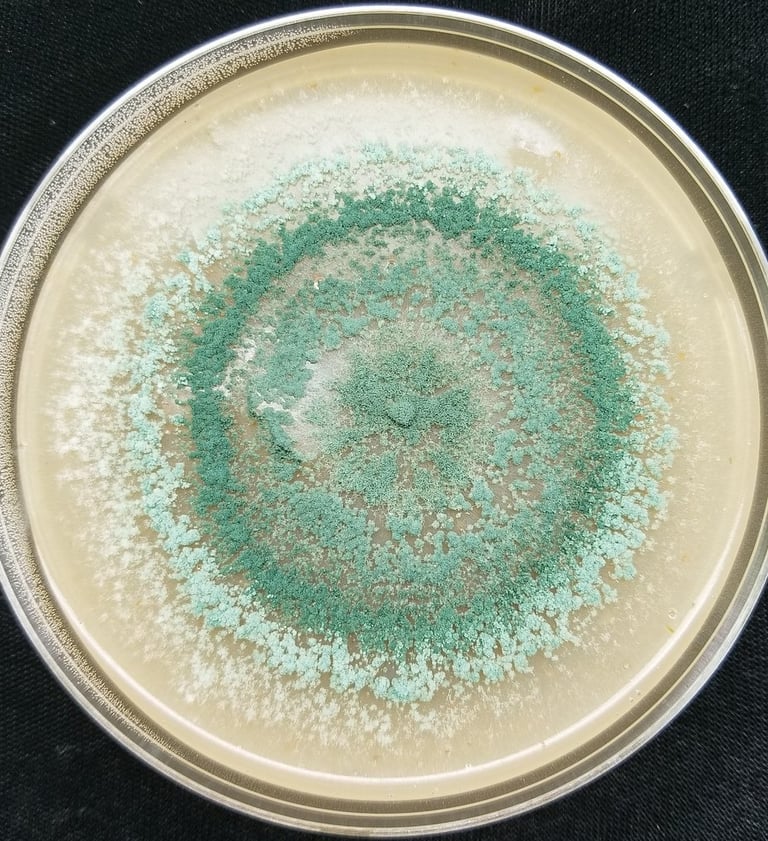

Servicios para pacientes de primera vez
Todo el instrumental de podología está esterilizado y el material es 100% desechable.




Onicocriptosis Grado I y II
$625 o solo $562.50 con el 10% de descuento pagando en efectivo o transferencia.
Se genera un expediente clínico.
Se realiza la valoración de sus pies para determinar las causas que originaron los síntomas que presenta.
Se resuelve el problema eliminando la espícula (pequeña parte de la uña que lastima la piel, razón del dolor).
Se realiza una curación.
Se emiten las recomendaciones pertinentes.
Este tipo de procedimientos es rápido e indoloro. Generalmente, no requiere anestesia o, en su defecto, se resuelve con anestesia tópica (gel o gotas).
Consulta podológica
$625 o solo $562.50 con el 10% de descuento pagando en efectivo o transferencia.
Se genera un expediente clínico.
Se realiza la valoración de sus pies.
Se emiten las recomendaciones pertinentes.
Se incluye el servicio de quiropodia, el cual consiste en:
Corte y limado de uñas.
Remoción de callosidades.
Aplicación de crema humectante.


Onicocriptosis grado III o IV
$900 o solo $810 con el 10% de descuento pagando en efectivo o transferencia.
Se genera un expediente clínico.
Se realiza la valoración de sus pies para determinar las causas que originaron los síntomas que presenta.
Se desensibiliza con crioterapia y se anestesia la mitad del dedo con anestesia local aplicada en la base del dedo, esto con el fin de evitar que el paciente presente dolor.
Se resuelve el problema eliminando la espícula (pequeña parte de la uña que lastima la piel, razón del dolor).
Se realiza una curación.
Se emiten las recomendaciones pertinentes.
En algunos casos, es necesario cauterizar granulomas o tejido de proliferación fibrosa para evitar cicatrices protuberantes o recidivas.


Aplicación de ampolleta extra de anestesia en onicocriptosis grado III y IV
Costo extra de $ 150 pesos con tarjeta o efectivo.
Se requiere una ampolleta para anestesiar la mitad de un dedo. En los casos de onicocriptosis grado III y IV (se cobran $900 por el servicio inicialmente), cuando es más de un lado de una uña, se agregan $150 por cada lado extra.


¡Libérate de las Verrugas!
Diferentes tratamientos
Los costos varían según el tipo de tratamiento.
Un tipo de tratamiento es resecar semanalmente la lesión con ácido nítrico. El costo de cada sesión es de solo $ 150 pesos.
El tiempo requerido con este tratamiento puede variar entre 4 hasta 12 sesiones dependiendo del tamaño y la respuesta metabólica.
El tratamiento con CANTARID consiste en la aplicación del medicamento y en la segunda cita antes de 48 horas acudir a la remoción definitiva de la verruga. El costo de este método es de $500 pesos, en caso de ser varias verrugas el costo se calculará acorde al área de afectación.








Servicio a domicilio
Los costos serían iguales al de una consulta más un extra acorde a la distancia.
Esté servicio, es únicamente para pacientes que por alguna condición médica (Fractura de cadera, ECV, parálisis corporal, etc.) les es imposible deambular. (Sin excepciones)
Las citas se deben acordar con un mínimo de 24 a 48 horas antes.
Remoción de gelish solo $ 100 pesos



Servicios de seguimiento para pacientes con expediente
Busca un espacio limpio y tranquilo, donde puedas sentirte seguro y confiado sabiendo que estás en las mejores manos.




Corte de uñas pediátrico
Paga solo $225 pesos por el corte preventivo de sus uñas.
¡Trae a tus hijos menores de 12 años y cuida de sus uñas con nuestro servicio de corte pediátrico!
Corte de uñas preventivo (forma recta).
Este servicio es solo preventivo, no incluye uñas encarnadas.
Este servicio es para menores de 12 años.
Servicio de quiropodia
$500 o solo $450 con el 10% de descuento pagando en efectivo o transferencia
Este servicio es para pacientes subsecuentes que cuentan con su expediente clínico y siguen las recomendaciones de su consulta.
El servicio consta de:
Corte y limado de uñas.
Remoción de callosidades.
Aplicación de crema humectante.
El período ideal suele oscilar entre 1 y 3 meses, dependiendo de la velocidad de crecimiento de las uñas.
Colocación de guías plásticas con acrílico
Solo $250 pesos por cada guía. (Un lado)
Una vez removida la espícula se da un tiempo para que la piel este sana.
Con la piel sana se coloca una guía plástica en el borde lateral de la uña.
Con la guía puesta se rellena de acrílico la parte faltante de uña.
Se aplica luz Ultravioleta para un mejor secado del acrílico.
Se emiten las recomendaciones pertinentes.
Este tipo de procedimientos es rápido e indoloro.
Se ofrece una garantía de 10 días en caso de que se caiga o pierda el acrílico para colocarlo nuevamente sin costo extra.
Servicio de Revisión
Este servicio es gratuito y está disponible únicamente para pacientes que ya cuentan con un expediente.
Es válido solo por 10 días después de haberse realizado algún procedimiento o servicio.




Quiro=manos y Podia=pies
Es el atender los pies con las manos.


Procedimientos quirúrgicos de las uñas
Soluciones definitivas para los molestos problemas de uñas incarnadas.


Tratamientos para Onicomicosis
Los hongos en las uñas son infecciones que pueden deformar las uñas y tener consecuencias, consulta la gama de tratamientos que existen actualmente y comienza el tratamiento más adecuado para tí.


Tratamiento Láser Avanzado para Onicomicosis
La onicomicosis (hongos en las uñas) es una infección persistente que tradicionalmente requería meses de pastillas fuertes o cremas que no siempre funcionan. En mi consulta, he revolucionado este proceso utilizando tecnología láser de doble acción, eliminando el hongo desde el interior sin poner en riesgo tu salud.


¿Cómo funciona mi tecnología láser?
No todos los láseres son iguales. Para asegurar la eliminación del hongo, combino dos de las tecnologías más potentes del mercado:
1. Efecto Fotoacústico (ND-YAG 1064nm)
Este láser es el "estándar de oro" médico. A diferencia de los láseres comunes, emite pulsos ultrarrápidos que generan un efecto ultrasónico.
La ciencia: La energía fragmenta mecánicamente las estructuras del hongo y rompe sus moléculas de agua.
El beneficio: Destruye el hongo por vibración y presión en las capas más profundas donde nadie más llega, sin quemar la piel.


2. Fototermólisis y Bioestimulación (Diodo 980nm)
Este equipo complementa el tratamiento mediante calor controlado y luz de alta intensidad.
La ciencia: Eleva la temperatura del hongo hasta desnaturalizar sus proteínas.
El beneficio: Además de eliminar el hongo, su luz estimula la microcirculación de la zona, lo que acelera el crecimiento de una uña nueva, fuerte y brillante.



Ventajas de mi tratamiento láser exclusivo
Atención 100% Profesional: Como único podólogo a cargo, yo mismo realizo el diagnóstico y calibro los equipos según tu tipo de uña.
Sin Medicamentos: Ideal si padeces de diabetes, hipertensión o si simplemente quieres evitar el daño hepático de los fármacos orales.
Rápido y Seguro: Sesiones de 15 a 20 minutos. Sin anestesia, sin dolor insoportable y sin tiempo de recuperación.
Efectivo: Resultados visibles conforme crece la uña sana.
¿Qué incluye tu sesión?
Valoración inicial: Determino el grado de infección y el tipo de hongo.
Aplicación de Láser: Uso personalizado del ND-YAG o Diodo (o combinación de ambos).
Plan de prevención: Te entrego las pautas para que el hongo no regrese jamás.
Costo por sesión: $500 de 1 a 5 uñas, $650 de 6 a 10 uñas. Inversión mínima para una solución definitiva.
Terapia de FotoBioModulación
Aprovecha esta tecnología y mejora tu salud.


1 sesión $ 350 pesos
5 sesiones por solo $ 1,500 pesos.
Disminuye el dolor, reduce la inflamación, acelera los procesos de cicatrización, regenera las células, aumenta la circulación, los nutrientes y la oxigenación de los tejidos.
Estudio de KOH (Diagnóstico de Hongos) 🔬
¿Qué es? Es una prueba donde analizamos una pequeña muestra de la uña bajo microscopio.
💰 Costo: Solo $249.
✅ Ventaja: Evitas gastar en medicamentos si no es necesario


Cultivo Micológico Ungueal. (Diagnóstico de Hongos) 🔬
¿Qué es? Es una prueba donde hacemos crecer el hongo para verlo y saber exactamente de cual se trata.
💰 Costo: Solo $485 pesos
✅ Ventaja: Evitas gastar en medicamentos si no es necesario

Cuidado Podológico Profesional
Ofrezco servicios de podología
integrales y personalizados.
Contacto
* Las promociones del 10% de descuento en efectivo o transferencia no aplican en tarjetas de regalo, cupones o códigos de descuento.
English spoken
